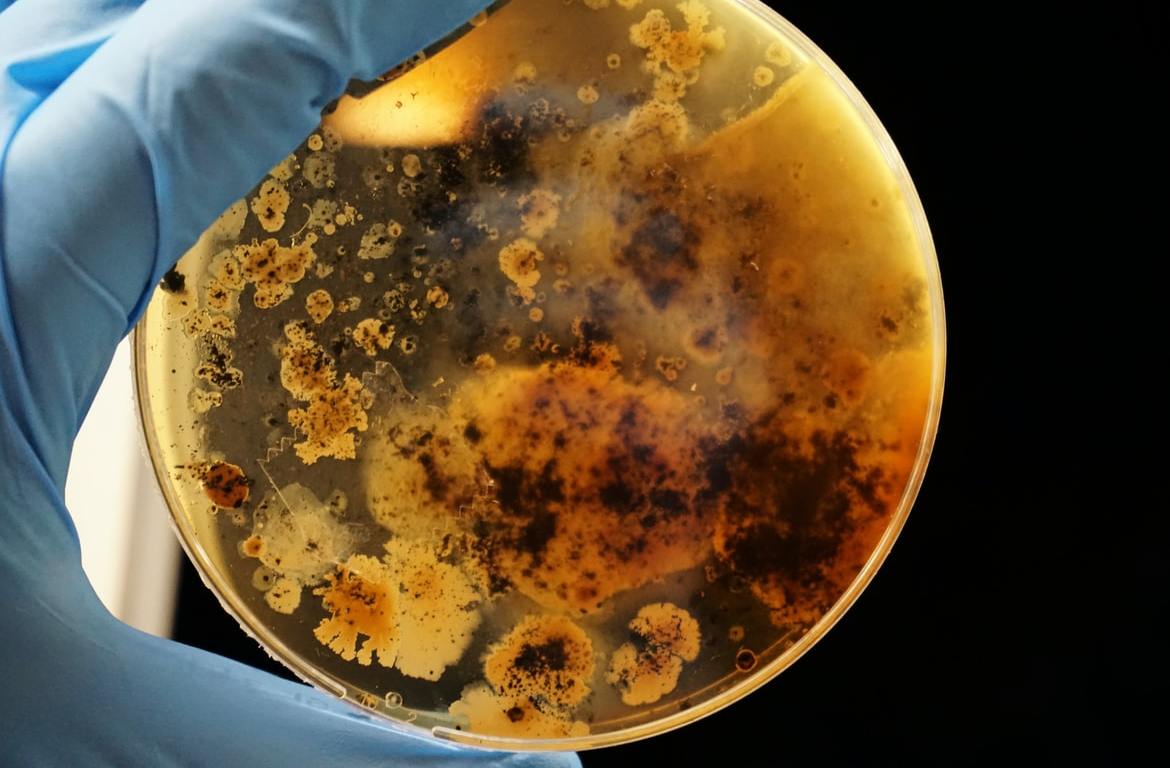

Sooraj Shah ’24

About 3 million Americans have been diagnosed with Crohn’s disease, a type of inflammatory bowel disease (IBD), with foreboding statistics indicating a rise in the disease’s prevalence. Crohn’s disease debilitates a patient through inflammation of the digestive tract, leading to severe pain and cramping in the abdominal area. The inflammation associated with the IBD is a response to invading pathogens by a group of proteins called cytokines. The function of cytokine interleukin-17A (IL-17A) has become the primary focus of combating this disease. A study led by Dr. Pawan Kumar, an Assistant Professor in the Department of Microbiology and Immunology at Stony Brook University, focused on identifying a beneficial function of IL-17A previously not recognized in standard treatments.
Previous research has shown that the body releases IL-17A when it detects microbial pathogens, signaling through other molecules such as the IL-17RA/IL-17RC receptor complex. Neutrophils and peptides, or associated white blood cells and defense molecules, respectively, then work to mitigate the pathogen. While monoclonal antibody treatment has been used to treat other inflammatory response-related diseases like psoriasis, this treatment resulted in increased disease for patients with Crohn’s disease, hinting that IL-17A plays a larger role in the proper functioning of intestinal tissue. To investigate the mechanisms behind this finding, Dr. Kumar and his team injected IL-17A into a variety of mice models and human organoids and observed the molecule’s role in specific functions of the intestinal tract.
The results of the study showed that IL-17A assists in the differentiation of stem cells into epithelial cells that play a crucial role as a barrier between bacteria and body tissue in the gut. When this divisional barrier is disrupted, it results in inflammation. Therefore, impairing IL-17A results in a decrease in epithelial cell production and an increase in observed inflammation in Crohn’s disease. Dr. Kumar believes that a relationship between immune cells and stem cells exists, such that the integrity of the intestinal mucosa (moist tissue) is maintained in order to hinder inflammation.
Crohn’s disease is currently incurable; however, the study of IL-17A uncovered a crosslink between its potential functions in inducing or preventing inflammation in the intestinal tract. Finding a balance of treatment so that certain functions of IL-17A are preserved while others are impaired is the next important step for future research, bringing a reliable and efficient cure to Crohn’s one step closer.
Works Cited:
- P. Kumar, et al., IL-17RA-signaling in Lgr5+ intestinal stem cells induces expression of transcription factor ATOH1 to promote secretory cell lineage commitment. Immunity 55, 237-253 (2021). doi: https://doi.org/10.1016/j.immuni.2021.12.016.
- Image Retrieved from: https://images.unsplash.com/photo-1596051827487-7b3d6f6df842?ixlib=rb-1.2.1&ixid=MnwxMjA3fDB8MHxwaG90by1wYWdlfHx8fGVufDB8fHx8&auto=format&fit=crop&w=1170&q=80